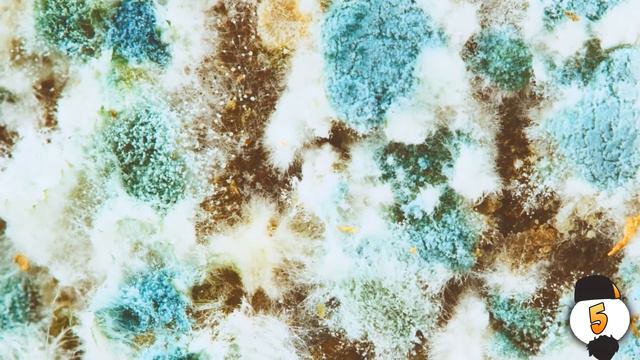
10 ФАКТОВ О СПАНЧ БОБЕ смотреть онлайн

Автор: Советы - Практика Страница 2

Снимаю видео с владиком в майнкрафт 4 часьть

ЭХ СЕЗ МАТУР КЫЗЛАР Татарский СВИСТ ТАТАРСТАН РОССИЯ Арск Атня Тюлячи Татеш Биектау

КТО ТВОЙ ПАПОЧКА В МАЙНКРАФТ ПЕ!

Короче говоря я решил стать Блогером

«Письмо Победы» для ветерана

Бесплатная раздача токенов MUSK в MuskSwap airdrop. BSC BEP20. С 01.01.22

Bang cash, зарабатываем деньги .

вечеринка в метелице 2001

World GN Загрузка документов и прописание банковских реквизитов

Zivert feat M'Dee двусмысленно cover

ХОНКАЙ СТАР РЕЙЛ СТРИМ №24 / ПРОХОЖДЕНИЕ №26 / ЯПОНСКАЯ ОЗВУЧКА / СТЕЛЛА / HONKAI: STAR RAIL STREAM

#31. Про КРУГ ОБЩЕНИЯ в материнстве

Ольга Усова - "Моя любовь"

«Авангард» - СКА 3:2. Послематчевая пресс-конференция

Вован поет "Владимирский централ" на стриме,Шок!,такого еще небыло на ютубе!

Здесь играет модная музыка 2018
10 ФАКТОВ О СПАНЧ БОБЕ

LADYBOMB 2016 | ХОЧУ БЫТЬ ХОРЕОГРАФОМ | КОРНЕВА ОЛЬГА

цена за клики facebook москва

День Победы 10 05 16

~..О,дрянь которую никто не любит?)..~

Николай уделывает Америку (05.05.2018.) Часть 2 )

НОВЫЕ ПРЕДСТАВИТЕЛИ ЗАКОНА (амазинг рп)

The World Shares in America’s 2020 Memorial Day | a JaYoe Conversation
За каждым успешным каналом стоит личность, идея и сотни часов кропотливого труда. Если вы здесь, значит, автор «Советы - Практика» уже сумел зацепить ваше внимание своим уникальным стилем или подачей. А мы на RUVIDEO позаботились о том, чтобы вы могли изучить весь архив его работ в максимально комфортных условиях — без лишней суеты и преград.
Почему за работами канала «Советы - Практика» так интересно наблюдать? Всё просто: это честный контент, который находит отклик в сердцах зрителей. На нашем ресурсе вы можете смотреть онлайн все видео любимого автора бесплатно и в хорошем качестве. Нам важно, чтобы вы видели каждую деталь и слышали каждый нюанс, поэтому мы используем только стабильные плееры из открытых источников Rutube.
Следите за новинками канала, пересматривайте старые шедевры и открывайте для себя новые грани творчества «Советы - Практика». Мы постоянно обновляем ленту, чтобы у вас под рукой всегда были самые свежие выпуски. Никаких сложных регистраций — только вы и творчество, которое вдохновляет. Приятного вам путешествия по миру авторского контента на RUVIDEO!
Видео взято из открытых источников Rutube. Если вы правообладатель, обратитесь к первоисточнику.